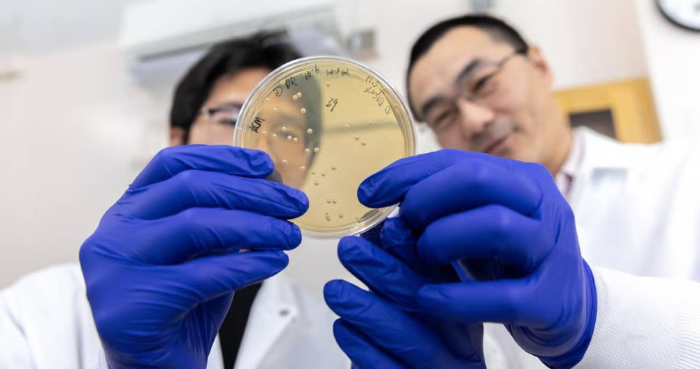

New bio-tech focuses on extracting rare earth elements from US wastewaters
- By Web Desk -
- Dec 17, 2025
A new federally funded research project at the University of California, Davis, focuses on extracting rare earth elements for modern technologies. This is from an unlikely source: acidic wastewater from mines and industrial processes.
The U.S. Department of Energy’s Advanced Research Projects Agency-Energy (ARPA-E) has granted UC Davis researchers a $3 million award. The funds are to develop a bio-based process that captures rare earth elements from acidic waste streams.
Led by Yi Wang, an assistant professor in the Department of Biological and Agricultural Engineering, the project aims to solve a crucial supply chain issue involving the extraction of rare earth elements.
Rare earth elements are vital for high-efficiency magnets in electric vehicles, wind turbines, and advanced electronics. However, conventional extraction methods are chemically intensive and generate substantial waste. The UC Davis team plans to engineer acid-tolerant microbes that produce metal-binding proteins, enabling low-cost recovery directly from low-pH environments.
Wang stated, “This technology aims to turn a liability into a resource. By selectively capturing rare earths where acidic wastewater is generated — like acid mine drainage — we can reduce chemical use and waste. This strengthens a resilient domestic supply chain for clean-energy manufacturing.”
The project will leverage artificial intelligence to design these proteins. Justin Siegel, a professor in the Department of Chemistry and co-principal investigator, explained that AI-guided design allows the team to “tune” protein binding loops. These loops will remain fast and highly selective even in harsh, acidic conditions.
By deploying these engineered biocatalysts in acid-tolerant microbial hosts, the team hopes to achieve a simpler, cleaner route. This route contributes to the extraction of rare earth elements from dilute waste streams.
The project extends beyond core scientific research, including a dedicated effort to transition from laboratory discoveries to real-world applications.
“Our goal is to ensure this remains more than just a promising idea on paper,” said Boon-Ling Yeo, co-principal investigator and leader of the tech-to-market initiative at UC Davis.
“We are considering costs, identifying markets, and exploring potential partners to make the recovery of rare earth elements from wastewater not only technically viable but also economically appealing.”
In addition to UC Davis investigators, the project involves collaborators Libin Ye from the University of South Florida. It also includes Ning Sun and Chang Dou from Lawrence Berkeley National Laboratory.
The funding is part of ARPA-E’s larger $25 million RECOVER program. This program aims to decrease American dependence on critical mineral imports by establishing secure, domestic supply chains.
